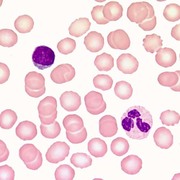

Learn Hématologie
Study Hématologie using smart web & mobile flashcards created by top students, teachers, and professors. Prep for a quiz or learn for fun!
Brainscape Certified flashcards
(0)
Decks
Flashcards
Learners
User Generated flashcards
(30)
Decks
Flashcards
Learners
-
Hematologie
Hematologie
By: Marius Rot
Anemiile Microcitare, Anemiile Macrocitare, Anemia Hemolitica3Decks89Flashcards1Learner -
Hématologie examen 2
Hématologie examen 2
By: Raphaëlle Tétreault
Hémostase normale, Labos des sd hémorragiques, maladies hémorragiques présentation ...10Decks409Flashcards1Learner -
Hématologie
Hématologie
By: Stephanie Roussel
Sang1Decks21Flashcards2Learners -
0. Hématologie

0. Hématologie
By: Laura Marlier
Cours Gulbis, Motte- Hémostase et troubles de la coagulation, Meuleman - hémopathie maligne ...8Decks356Flashcards2Learners -
Hematologie 3 exam 2
Hematologie 3 exam 2
By: Anabelle Laplante
chapitre 38 moelle osseuse, chapitre 37 colorations spéciales, cytofluorimétrie3Decks174Flashcards1Learner -
Hématologie

Hématologie
By: Arthur Flausse
Granulopathie fébrile, Thrombopénie - Transfusion plaquettaire2Decks26Flashcards1Learner -
Hématologie et Immunologie pour SF
Hématologie et Immunologie pour SF
By: Raphaëlle Poulin
Hématologie, Anémie, Hémostase ...6Decks322Flashcards10Learners -
💊Hématologie stage examen III
💊Hématologie stage examen III
By: Claudie Furlong
Introduction hémostase, Spécimen, Hémostase primaire ...15Decks567Flashcards2Learners -
KOW - Hematologie
KOW - Hematologie
By: Carmen de la Cruz Tortosa
VTE (Veneuze trombose en embolie), Bloedingsziekten bij volwassenen en kinderen, Overige hematologische problematiek3Decks141Flashcards3Learners -
Keuze onderwijs Hematologie
Keuze onderwijs Hematologie
By: l g
Introductie, Veneuze trombose en embolie, Bloedingsziekten bij volwassenen en kinderen ...4Decks213Flashcards1Learner -
Hématologie
Hématologie
By: Céline Gettemans
NFS/Hémogramme, Hématologie adulte - Chapitre 1, Hématologie adulte - Chapitre 4 ...6Decks54Flashcards1Learner -
hématologie
hématologie
By: Miam Miam
maladie de Willebrand, Hémophilie, polyglobulies I ...25Decks239Flashcards1Learner -
Hématologie
Hématologie
By: benjamin popoff
311-Eosiniphilie, 297-Anémie, 316-Hemogramme ...19Decks159Flashcards3Learners -
Hematologie 3 exam 1
Hematologie 3 exam 1
By: Anabelle Laplante
qualité, instrumentation introduction, réticulocytes ...5Decks62Flashcards1Learner -
Hématologie
Hématologie
By: Lucie Rgldr
Transfusions, LLC, Thrombopénie ...6Decks145Flashcards2Learners -
Hématologie

Hématologie
By: Ana Gavric
Hématologie, Système respiratoire2Decks22Flashcards1Learner -
KOW benigne hematologie
KOW benigne hematologie
By: Evie Brakel
biochemie en celbiologie van de bloedstolling, Veneuze trombose en embolie (VTE), bloedingsziekten bij volwassenen en kinderen ...4Decks147Flashcards1Learner -
Hématologie stage examenII
Hématologie stage examenII
By: Claudie Furlong
Amémie Résumer, Valeurs normales, LCR ...20Decks297Flashcards1Learner -
Hématologie
Hématologie
By: Amélie H
Hématopoïèse1Decks61Flashcards1Learner -
Hématologie

Hématologie
By: Maeva Michaud
Leucémies Aigues, Immunoglobuline, Hemostase ...16Decks122Flashcards2Learners -
Hematologie 3 Exam 2
Hematologie 3 Exam 2
By: Catherine Desjardins
Meolle Osseuse, Études Spéciaes Sur La Moelle Osseuse, Tabelau Résumer Moelle ...5Decks178Flashcards1Learner -
Hématologie
Hématologie
By: Alice Pornin
ANÉMIES CARENTIELLES, ANÉMIES HÉMOLYTIQUES, LMC, LLC ...10Decks199Flashcards1Learner -
Biologie 2 : Hematologie
Biologie 2 : Hematologie
By: CHONKY BOI
Hoofdstuk 1, Hoofdstuk 2, Hoofdstuk 3 ...5Decks180Flashcards1Learner -
Hématologie
Hématologie
By: Amélie Hoarau
Pathologies de la coagulation1Decks28Flashcards1Learner -
Hematologie
Hematologie
By: Ceylo Smits
Fysiologie, Hemostase, Bloedgroepen ...8Decks119Flashcards2Learners -
Hématologie
Hématologie
By: Erica Savoie
Instrumentation, Hématologie anomalies (RT)2Decks486Flashcards2Learners -
Hématologie

Hématologie
By: Marjorie Potvin
Chapitre 1,2,3,4, Chapitre 8 : Les anémies, Ch.6-7 intro aux maladies du sang ...4Decks104Flashcards1Learner -
Hematologie-H
Hematologie-H
By: H. JG
Lab 4- instrumentation et moelle, Test 2, Coloration spéciales ...5Decks186Flashcards2Learners -
Hématologie
Hématologie
By: LUHERNE Vincent
Hémato11Decks83Flashcards4Learners -
Hématologie
Hématologie
By: Nicole Crevier-L.
Anémie, Leucocytes, Hémostase3Decks226Flashcards2Learners



